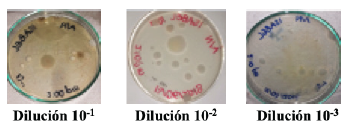
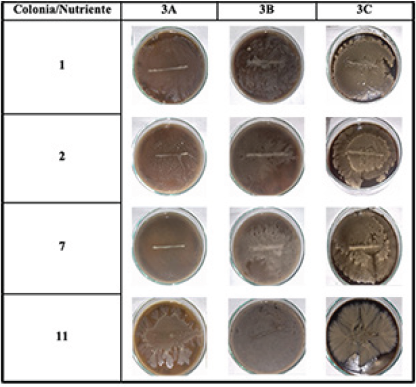

1. Introducción
La bioprecipitación inducida es un proceso que ocurre cuando los microorganismos nativos del suelo o introducidos en éste, forman precipitados de minerales cristalinos o amorfos, específicamente de carbonatos, lo que se conoce como "Carbonatogénesis" (Lee, 2003). Se ha podido establecer que la bioprecipitación puede ocurrir mediante diferentes vías, las cuales tienen en común la producción de dióxido de carbono (CO2) metabólico y amoniaco (NH3), que en presencia de iones de calcio (Ca2+) resultan en la liberación de amonio y en la precipitación de carbonato (Valencia et al., 2014). Cuando se efectúan los procesos necesarios para la respiración microbiana se generan los iones carbonato y bicarbonato que provienen de la solubilización del CO2. Una vez la bacteria interactúa con la fuente de Ca2+, éste se acerca a la pared celular del microorganismo por su electronegatividad donde ocurre la nucleación y debido a la reacción con el CO3 2- se produce el precipitado de CaCO3 (Stocks et al., 1999).
Para lograr la bioprecipitación se han empleado diferentes formas de incrementar los rendimientos de la técnica, tales como introducir poblaciones de bacterias con capacidad de bioprecipitar en el suelo (Montoya et al., 2005) o estimulando los microorganismos nativos mediante la adición de nutrientes considerando diferentes variables como el pH, el tipo de microorganismos y sus requerimientos nutricionales. En el caso de nuestro país el nutriente más empleado como potenciador de este proceso es el B4, que se compone de acetato de calcio, extracto de levadura, glucosa y agar (Garcia et al., 2016).
En Colombia, el proceso de bioprecipitación inducida es costoso, debido a que los componentes para elaborar el B4 tienen valores elevados en el mercado. Es por ello que los esfuerzos se han enfocado en proponer alternativas más económicas de modo que se puedan reemplazar los elementos de dicho nutriente (Valencia, 2009), por productos que cumplan los mismos objetivos pero más accesibles, tales como la cachaza de caña de azúcar que es un residuo proveniente del proceso productivo de la panela y se genera en grandes volúmenes. Se estima que por cada cien toneladas de caña molida se obtienen tres toneladas húmedas de ésta, lo que representa una gran problemática para su disposición (Salamanca, 2018).
La cachaza de caña es de coloración café oscura y se compone de sacarosa, fosfato de calcio, fibras de la caña y algunos coloides. Es rica en componentes indispensables para el desarrollo del metabolismo microbiano y en fuentes asimilables de carbono, calcio, nitrógeno y materia orgánica (Baskar et al., 2006). La cantidad en la que se produce y su composición la hacen una buena candidata para elaborar el nutriente que simule las características del B4.
Diversos estudios (Montoya et al., 2005; Valencia, 2014; Baskar et al., 2006; Cezario et al., 2017; Van der Star et al., 2001; van Paassen et al., 2010; Canakci et al., 2015) han demostrado que la bioprecipitación inducida tiene diversas aplicaciones para lograr un mejoramiento en las propiedades físicas y mecánicas en suelos de diferentes tipos. Esta variedad en la composición de los suelos también se ha empleado para optimizar la capacidad portante de un terreno (Capote, 2019) o para mejorar técnicas de construcción con tierra como es el caso de los bloques de tierra comprimida (BTC). Estos bloques son una mezcla de arcilla, limo y arena, la cual puede ser compactada de forma manual o mecánica (Hernandez et al., 2015). Los BTC permiten un ahorro energético y económico importante, generalmente pueden ser elaborados in situ evitando sobrecostos por transporte, no requieren cocción como los adobes convencionales y permiten la utilización del material procedente de excavaciones del lugar de construcción o de otros proyectos (Arteaga et al., 2012). Debido a esto, es común que se efectúen ensayos de contenido de humedad, granulometría, compactación y límites de consistencia al suelo para determinar sus características iniciales. Además, una vez elaborados los bloques se someten a pruebas de laboratorio que permiten estimar su resistencia a diferentes tipos de esfuerzos. Las más comunes son la de compresión incofinada, de capilaridad y de abrasión hídrica (van Paasen et al., 2010). Además de promover prácticas más amigables con el medio ambiente, al usar estos bloques se da una disminución considerable tanto en los costos de construcción como en el valor final del inmueble, lo que posibilita que personas de escasos recursos puedan tener acceso a una vivienda digna (Galíndez, 2007); sin embargo, aunque la utilización de los BTC se presenta como una buena solución para la construcción de edificaciones más económicas y sostenibles, es necesario considerar ciertos factores que aún representan desafíos por resolver. Se ha demostrado que el material tiene alta resistencia a la compresión, pero el principal reto es mejorar su resistencia cuando es sometido a fuerzas de tracción ante la ocurrencia de un sismo (Rocha y Sandoval, 2015). También es necesario considerar que el material se agrieta o se degrada por la acción erosiva del agua y sufre abrasión por humedades extremas comprometiendo la estabilidad de la estructura.
Es por ello que para mejorar las propiedades físicas y mecánicas de los BTC en este estudio se realizó la bioprecipitación inducida del carbonato de calcio empleando un nutriente a base de cachaza de caña de azúcar y cal común.
2. Metodología
2.1 Localización y recolección de las muestras de suelo
Se tomaron tres muestras de suelo en un proyecto urbanístico realizado en el municipio de Envigado-Antioquia durante la construcción de las pilas (Figura 1). Las coordenadas de los puntos 1, 2 y 3 de muestreo fueron 6°10'04.5"N 75°34'27.7"W, 6°10'05.0"N 75°34'27.3"W y 6°10'04.3"N 75°34'27.0"W, respectivamente.

Figura 1 Localización del lugar de extracción de la muestra; proyecto urbanístico en el municipio de Envigado-Antioquia. Fuente: Google Maps.
Para la toma de muestras, en los tres puntos seleccionados, se definió un área de 3m x 3m y siguiendo una forma de zigzag se tomaron 15 muestras de 1 kg cada una. Éstas se tomaron alteradas a una profundidad de 3m, para evitar extraer un alto contenido de materia orgánica. Posteriormente, fueron transportadas en bolsas plásticas a prueba de humedad al laboratorio de suelos y pavimentos de la Facultad de Ingeniería de la Universidad de Antioquia, siguiendo las recomendaciones de la norma INV E 103-13 para muestras del grupo B y se almacenaron en un cuarto de curado a temperatura ambiente hasta su análisis.
2.2 Caracterización física del suelo
Para determinar el contenido de humedad de las muestras se siguió lo establecido por la Norma ASTM D2974 para el método del horno. En cuanto a los límites de consistencia (Atterberg) y establecer la humedad correspondiente a los límites líquido y plástico se efectuaron los pasos descritos en la Norma ASTM D4218. El análisis granulométrico de tamizado mecánico e hidrómetro se ejecutó con base en la Norma ASTM D422 y la determinación del contenido óptimo de humedad se realizó con base en la Norma ASTM D-698 para el ensayo de proctor estándar. Se evaluaron nueve puntos diferentes de humedad 10, 14, 17, 18, 20, 22, 25, 27 y 29 % definidos respecto al peso de la muestra para cada punto (3 kg). Se efectuaron tres ensayos por duplicado en cada caso.
2.3 Aislamiento de los microorganismos del suelo
Para el aislamiento de bacterias con posible capacidad precipitadora de CaCO3, en su mayoría bacilos Gram positivos esporulados, se siguió la metodología propuesta por Ohba y Aizawa (1986) y se realizó dos veces, el primero se hizo 24 horas después de recolectada la muestra y el segundo una semana después. De una muestra de suelo compuesta se tomaron 10 g, se mezclaron con 90 mL de solución salina al 9% estéril y se llevó a baño maría a una temperatura controlada de 60°C durante 10 min, e inmediatamente fue sumergido en hielo a una temperatura de 4°C, por el mismo periodo de tiempo, con el fin de generar un choque térmico para las células. A partir de dicha mezcla se realizaron diluciones seriadas con solución salina hasta 10-5 en el caso del primer aislamiento y hasta 10-3 en el segundo. De cada dilución se tomaron 100 μL, y se sembraron por superficie en agar nutritivo con asa Digralsky. Las cajas de Petri se incubaron a 35°C por 24 h. Pasado el tiempo de incubación, se seleccionaron las colonias con características macroscópicas diferentes como: textura, pigmentación o color, borde, consistencia y características ópticas. Las colonias seleccionadas fueron sembradas por agotamiento para la obtención de cultivos axénicos y se incubaron manteniendo las condiciones anteriormente mencionadas. Se realizaron tinciones de Gram para cada cultivo axénico con el fin de verificar la morfología y su respuesta al Gram. Finalmente, a los cultivos formados por bacilos Gram positivos se les hicieron pruebas de catalasa siguiendo la metodología reportada por Koneman et al. (2008), ya que sugieren que la aparición rápida de efervescencia indica la producción de oxígeno molecular y un posible resultado positivo para bacilos Gram positivos. Sobre un portaobjetos se puso una gota de H2O2 al 3 % (Merck) y en ésta se espació un poco de muestra para observar la reacción.
2.4 Recolección y caracterización del sustrato
La cachaza de caña se recolectó en el trapiche panelero "Santa Rita", localizado en la vereda "Las Encarnaciones" del municipio de San Roque-Antioquia. Una vez que el sustrato se encontraba a temperatura ambiente se tomó directamente del caldero donde se recolectaba durante el proceso productivo y se depositó en una botella plástica de 3L. Ésta se transportó y se almacenó hasta su análisis en una nevera a temperatura de 4°C, con el fin de evitar la fermentación de la muestra. Se realizaron análisis fisicoquímicos de pH y Demanda Química de Oxigeno (DQO), siguiendo las metodologías establecidas en el Estándar Métodos (APHA, 2017).
2.5 Elaboración del nutriente y los montajes experimentales
Se siguió la metodología usada por Valencia (2009) para el B4 y con base en ésta se realizaron los cálculos estequiométricos para cada uno de los componentes. Para remplazar la glucosa y preparar 1L del nutriente se partió de la composición de la cachaza, ya que según FEDEPANELA el contenido de sacarosa es de 21% aproximadamente. El equivalente a 5 gramos de glucosa son 9.5 gramos de sacarosa aportada por la cachaza. De forma similar se procedió con la cal común para sustituir el acetato de calcio y se encontró que la cantidad requerida eran 7.03 gramos de cal. Se hicieron tres montajes para determinar las proporciones adecuadas de los elementos que componen el nutriente para lograr el crecimiento microbiano y la precipitación de CaCO3.
En el primer montaje se usaron las relaciones que se muestran en la tabla 1 con el fin de analizar la incidencia de cada componente sobre el crecimiento bacteriano y la precipitación del carbonato de calcio. En este caso no se realizó ningún ajuste del pH en el medio de cultivo y las muestras se dejaron incubando a 35 °C por 15 días.
Tabla 1 Componentes utilizados y sus respectivas variaciones empleados en el montaje.
| Nutriente | Agar (g) | Extracto de levadura (g) | Cal (g) | Cachaza de caña (mL) | Agua destilada (mL) |
|---|---|---|---|---|---|
| 1* | 12 | 4 | 7.03 | 41.09 | 958.91 |
| 1A | 8-03 | ||||
| 1B | 6.03 | ||||
| 2A | 7.03 | 46.00 | 954.00 | ||
| 2B | 36.09 | 936.91 | |||
| 3A | - | 50.00 | 950.00 | ||
| 3B | - | 100.00 | 900.00 | ||
| 3C | - | 500.00 | 500.00 |
*Concentración teórica de la bibliografía.
El segundo montaje experimental consistió en evaluar la incidencia del pH sobre la precipitación de CaCO3 (Tabla 2). Debido a que se deseaba evaluar el pH a 8, 9 y 10 y la cal aportaba alcalinidad, se llegó a dichas unidades con H2SO4 al 5 N. Las muestras se incubaron a 35°C durante 9 días.
Tabla 2 Componentes utilizados en el segundo montaje experimental para estimar la incidencia del pH.
| Nutriente | Agar (g) | pH | Cal (g) | Cachaza de caña (mL) | Agua Destilada (mL) |
|---|---|---|---|---|---|
| 3A | 12 | 8-9 -10 | 7.03 | 50 | 950 |
| 3B | 8 -9 -10 | 100 | 900 | ||
| 3C | 8 -9 -10 | 500 | 500 |
Para el primer y segundo montaje se tomaron los microorganismos obtenidos mediante el choque térmico y se hicieron las siembras. Para ello se usaron las colonias de población mixta y se sembró una línea recta en el medio de cultivo para facilitar la observación del halo de carbonato de calcio que se podría formar a su alrededor. Por otra parte, el tercer montaje consistió en evaluar los nutrientes 3A, 3B y 3C a un pH de 8 usando las siembras de cultivos axénicos de las colonias seleccionadas, con el fin de analizar cualitativamente la producción de CaCO3 de cada una de ellas por separado. Se sembraron los microorganismos de forma similar a los dos montajes anteriores y se incubaron a 35°C durante 5 días. Finalmente, en los tres montajes se evaluó de forma cualitativa la formación de CaCO3 siguiendo lo sugerido por Valencia (2009), ya que reportó que se puede confirmar la presencia de éste mediante la aparición de efervescencia al agregar ácido clorhídrico sobre la muestra puesto que se produce dióxido de carbono. Sin embargo, se realiza una variación, puesto que Valencia (2009) realizó la prueba directamente sobre el suelo y en este caso se evaluó en el medio de cultivo. Para ello se tomó un portaobjetos y se agregó una gota de HCL al 30%, sobre ésta se esparció una pequeña cantidad de muestra tomada con un asa de siembra de los medios de cultivo una vez que finalizó la etapa de incubación.
2.6 Elaboración de las probetas
Debido a que son diversas las técnicas que se emplean para la construcción de bloques de tierra comprimida, se optó por no secar el suelo y humedecerlo hasta el promedio obtenido de las humedades resultantes de los ensayos del límite líquido y el límite plástico. Ello con el fin de simular las condiciones del material en campo y su contenido de humedad natural. Se realizaron 8 ensayos (Tabla 3) en total, con la finalidad de tener controles de referencia y verificar respecto a éstos si se daba un mejoramiento en la resistencia a los esfuerzos compresivos del suelo con adición del nutriente elaborado a base de cachaza de caña y cal.
Tabla 3 Ensayos de control usados para evaluar el mejoramiento en la resistencia a los esfuerzos de compresión.
| Ensayo | Condiciones de la muestra |
|---|---|
| Control | Suelo en condiciones de humedad natural sin adición de nutriente o cal |
| Control-Cal | Suelo en condiciones de humedad natural sin adición de nutriente y se le agregó el 5% de su peso en cal. |
| 3A(1) | Suelo con adición de un 2% de nutriente respecto a su humedad natural. Humedad Final 47 % = 45 % (Agua) + 2 % (Nutriente) |
| 3A(2) | Suelo con adición de un 4% de nutriente respecto a su humedad natural. Humedad Final 49 % = 45 % (Agua) + 4 % (Nutriente) |
| 3B (1) | Suelo con adición de un 2% de nutriente respecto a su humedad natural. Humedad Final 47 % = 45 % (Agua) + 2 % (Nutriente) |
| 3B(2) | Suelo con adición de un 4% de nutriente respecto a su humedad natural. Humedad Final 49 % = 45 % (Agua) + 4 % (Nutriente) |
| 3C (1) | Suelo con adición de un 2% de nutriente respecto a su humedad natural. Humedad Final 47 % = 45 % (Agua) + 2 % (Nutriente) |
| 3C (2) | Suelo con adición de un 4% de nutriente respecto a su humedad natural. Humedad Final 49 % = 45 % (Agua) + 4 % (Nutriente) |
Para elaborar las probetas que simularon los bloques de tierra comprimida se tomó como referencia la norma la ASTM D-1557 correspondiente al ensayo de Proctor modificado. En cada ensayo se tomaron 5 kg de muestra y se empleó el molde de 6" de diámetro con el pistón de 4.5 kg de peso que caía a una altura de 457 mm. Para el control sin adición de nutriente se agregó agua para llevar el suelo a 45% de humedad, definida respecto al peso de la muestra (5 kg). Se adicionó una capa dentro del molde y se le aplicaron 56 golpes en forma de espiral con el pistón, se escarificó. El procedimiento se repitió cuatro veces más de tal forma que el suelo quedara por encima del borde del primer anillo del cilindro. Se tomaron cuatro tubos shelby con el fin de obtener al menos tres muestras representativas, se lubricaron con ACPM y se martillaron sobre el suelo compactado para extraer las probetas (Figura 3). Una vez que éstas se sacaron de los tubos shelby se moldearon y se verificó que sus medidas cumplieran con la norma.
El control con cal se realizó adicionándole al suelo 5% de ésta, respecto al peso de la muestra (5 kg), se homogenizó y se agregó agua hasta que se consiguió una humedad del 45%. La muestra 3A (1) se hizo humedeciendo el suelo con agua hasta que se logró una humedad del 45% y seguidamente se agregó 2% del nutriente homogenizando la mezcla. De forma similar se procedió con las muestras 3A (2), 3B (1), 3B (2), 3C (1) y 3C (2) adicionando 2 y 4 % de nutriente según el caso. En todos los ensayos las probetas se elaboraron siguiendo la misma metodología del control. Finalmente, las muestras extraídas se dejaron en un cuarto de curado a 24°C por 28 días y posteriormente, se efectuaron ensayos de compresión simple siguiendo la norma ASTM D2166 para compresión simple de suelos cohesivos.
3. Resultados y discusión
3.1 Caracterización física del suelo
El suelo estudiado con el que se elaboraron las probetas fue clasificado como limo de alta plasticidad (MH) según el Sistema Unificado de Clasificación de Suelos (SUCS). Su contenido de humedad natural promedio fue de 37.93 % y los promedios obtenidos tanto para el límite líquido como para el límite plástico fueron 50.6 y 40.5 respectivamente (Tabla 4).
Tabla 4 Contenido de humedad natural y límites de consistencia del suelo recolectado en los tres puntos de muestreo.
| Punto | Contenido humedad natural (%) | LL* (%) | LP* (%) | IP* (%) |
|---|---|---|---|---|
| M1(A) | 37.58 | 50.7 | 40.7 | 10.0 |
| M1(B) | 37.50 | 51.1 | 40.3 | 10.8 |
| M2(A) | 37.11 | 50.8 | 40.6 | 10.2 |
| M2(B) | 37.84 | 50.3 | 40.3 | 9.9 |
| M3(A) | 38.94 | 50.2 | 40.7 | 9.5 |
| M3(B) | 38.60 | 50.5 | 40.4 | 10.2 |
*LL: Límite líquido; LP: Límite plástico; IP: Índice de plasticidad.
Adicionalmente, de los ensayos de granulometría e hidrometría se determinó que el suelo está compuesto en un 38.67 % por arenas de un tamaño entre 2.26 - 0.08 mm; un 56.94% de limo cuyas partículas tienen diámetros que van entre 0.075 -0.002 mm y finalmente un 4.30 % son arcillas con tamaños de partículas menores a 0.002 mm (Figura 2).

Figura 2 Curva de granulometría e hidrometría obtenida para el suelo usado en la elaboración de las probetas.
Según las especificaciones del USDA se puede clasificar la textura del suelo como franco limosa, lo cual indica que este material posee una buena capacidad de transferencia de oxígeno y retención tanto de agua, como de los nutrientes necesarios para que se den unas condiciones ambientales favorables para el desarrollo de los microorganismos en el suelo. Según Koneman et al. (2008), en un suelo poco oxigenado se incrementa la concentración de amonio, hierro y manganeso, lo que puede inhibir la población de microorganismos, además se disminuye la disponibilidad de elementos indispensables para el metabolismo microbiano como el calcio, magnesio y sodio, lo que se traduce en un suelo pobre en microfauna, limitando el proceso de bioprecipitación. Asimismo, la estructura del suelo mostró agregados granulares y migajosos de diversas coloraciones como amarilla, grisácea, roja y naranjada. Esta forma en la que se configuran las partículas permite que circule el agua y el aire, y facilita el intercambio catiónico que incide directamente en la disponibilidad de elementos necesarios para el crecimiento de los microorganismos. Por consiguiente, la estructura del suelo de interés da indicios de una buena actividad microbiana, ya que la presencia de microfauna contribuye a la estabilización de los agregados y éstos a su vez facilitan las condiciones ambientales para que los microorganismos proliferen.
3.2 Caracterización microbiológica del suelo
Como resultado del primer proceso de aislamiento bacteriano por choque térmico se obtuvo un conteo de microorganismos resultantes de 2 x 10-7 UFC/mL por cada 10 g de suelo analizado. Además, se evidenció que en el medio compuesto por agar nutritivo, se dio el crecimiento de colonias con tamaños variables, de forma circular y convexa, su color era blanco opaco, de textura granular y consistencia densa. Para el segundo aislamiento bacteriano que se realizó se obtuvieron las poblaciones de microorganismos que se muestran en la figura 3.
Figura 3 Segundo aislamiento bacteriano realizado del suelo proveniente de los 3 puntos de muestreo.
A partir de los crecimientos microbianos de la figura 3 se seleccionaron 11 colonias con características macroscópicas diferentes (Figura 4). Esto se hizo porque cada una de ellas crece a partir de una sola célula, lo que permite evaluar por separado cuáles de ellas tienen o no, la capacidad de generar carbonato de calcio al ser biostimuladas con el nutriente a base de cachaza de caña de azúcar y cal.

Figura 4 Colonias seleccionadas para elaborar cultivos axénicos y evaluar su potencial para precipitar CaCO3. a) Colonia 1. b) Colonia 2. c) Colonia 3. d) Colonia 4. e) Colonia 5. f) Colonia 6. g) Colonia 7. h) Colonia 8. i) Colonia 9. j) Colonia 10. k) Colonia 11.
En la figura 4ase observó que la colonia era de color blanco mate y de consistencia membranosa, sus bordes eran irregulares redondeados y creció de forma acuminada. La colonia de la figura 4b era de color blanco mate y consistencia densa, con bordes irregulares redondeados, su textura era casi homogénea donde se podía distinguir un centro y creció de forma convexa. En la creció una colonia de color beige brillante, consistencia densa, borde redondo, su textura era homogénea y de forma convexa. En cuanto a la figura 4d se evidencia que la colonia era de una coloración más oscura, opaca y de consistencia densa, se observó un centro redondo, liso y definido por una coloración más clara pero sus bordes eran irregulares redondeados, más oscuros y con textura granular. Además, creció de forma elevada. La colonia de la figura 4e era de color amarillo mate, densa y forma redonda, su textura era granular, especialmente en el centro de la colonia y creció de forma acuminada. En la figura 4f la colonia era de color blanco mate, densa y forma circular. Su textura era homogénea, con borde redondo y creció de forma convexa. La colonia de la figura 4g también era de color blanco mate y consistencia densa, pero con bordes irregulares redondeados, su textura era granular y creció de forma acuminada. En la figura 4h la colonia que creció era de color blanco mate, consistencia densa y forma circular, la textura era irregular y su borde redondo con forma elevada. Por otra parte, la colonia de la figura 4i era de color blanco, opaca, de consistencia membranosa, su textura era filamentosa y tenía bordes irregulares. En la figura 4j figuraera de color blanco mate, consistencia densa y forma circular con borde redondo, su textura era homogénea y creció de forma pulvinada. Finalmente, en la figura 4kse observó una colonia de color blanco opaco, consistencia viscosa y tenía forma de cruz, su textura era homogénea pero sus bordes eran filamentosos de un blanco más claro, además, creció de forma convexa.
A cada una de las colonias que se muestran en la figura 4 se les realizaron cultivos axénicos y a las poblaciones microbianas que crecieron en éstos se les hizo tinción de Gram para seleccionar solamente las células con formas bacilares y aquellos que fuesen Gram positivos, los resultados obtenidos de estas tinciones se muestran en la figura 5.
Exceptuando la figura 5e, se pudo observar que las características microscópicas eran propias de bacilos, ya que correspondían a células con forma de bastón, de tamaños variables y de coloración morada, lo que indicaba que además eran Gram Positivas. Teniendo en cuenta estas observaciones se descartó la colonia número 5 (Figura 5e) porque su tipo celular era en forma de cocos y dicha población no es de interés para realizar la bioprecipitación inducida. Estudios realizados por Montoya et al. (2005) y Valencia (2014), encontraron que los microorganismos nativos del género Bacillus, dan buenos rendimientos para la producción de carbonato de calcio y, además, no alteran las cadenas tróficas ni la microfauna del suelo, ya que al ser propios del ecosistema no presentan relaciones de competencia, antagonismo o inhibición entre la biomasa presente. Por consiguiente, se seleccionaron las 10 colonias restantes para confirmar los resultados encontrados, mediante la prueba de la catalasa. Los resultados arrojaron un resultado positivo para las 10 cepas, dicho resultado junto con la tinción de Gram respaldan que se trataban de microorganismos del género Bacillus (Larrea et al., 2015).
3.3 Caracterización del sustrato
La cachaza de caña tenía un pH de 7.4, valor que se encuentra en el rango de lo que han caracterizado autores como Salazar et al. (2009) y que indica que no se ha producido una fermentación de esta, ya que a medida que ocurre dicho proceso el pH tiende a acidificarse por acción de la formación de ácidos grasos volátiles. En cuanto al contenido de materia orgánica se determinó que la cachaza tenía una DQO promedio de 59.44 g/L y en investigaciones donde se ha estudiado este sustrato se han obtenido mediciones de hasta 63.00 g/L (Sabadí, 2007), concentración requerida por los microorganismos como donante de electrones para el proceso aerobio de degradación. Adicionalmente CORPOICA ha reportado que la cachaza puede tener contenidos de nitrógeno y fosforo de 0.45 g/L y 0.34 g/L respectivamente y estudios establecidos por Bohórquez et al. (2014) determinaron que esta tiene una relación C:N de aproximadamente 49.22:1.
3.4 Evaluación del nutriente
El primer montaje tenía como finalidad evaluar cuáles proporciones de los elementos que componen el nutriente tenían mejor incidencia sobre el crecimiento microbiano y la precipitación de CaCO3 y para ello se hizo un seguimiento durante 15 días (Figura 6).
En los nutrientes 1A, 1B, 2A y 2B no se evidenció un crecimiento importante de los microorganismos, lo cual está asociado a los requerimientos nutricionales de éstos, si bien los bacilos no son exigentes en cuanto a la demanda o especificidad de nutrientes, estos se pueden ver afectados por las altas concentraciones de ciertos elementos. En el caso de los nutrientes 1A y 1B se evaluó una concentración de cal por encima de la que reportaba la literatura para estimular la precipitación de CaCO3, lo que pudo incidir negativamente sobre la pared celular de las bacterias, sobresaturándola e impidiendo que éstas sobrevivieran en el medio. Prescott (1999) afirma que la estabilidad de la membrana celular se encuentra dada por los puentes de hidrógeno, las interacciones hidrofóbicas y por cationes como el magnesio y el calcio que interactúan con los fosfolípidos, por lo tanto, al presentarse un exceso de calcio aportado por la cal es factible que se rompiera dicho equilibrio y se sobresaturaran las células alterando sus funciones vitales. Con los nutrientes 2A y 2B se pretendía evaluar una concentración de glucosa menor a la reportada en la literatura debido a que se quería evaluar cuál era la cantidad más adecuada para suplirla con la cachaza de caña y al no evidenciarse un crecimiento de las bacterias en estos dos nutrientes se asume que esta situación se encuentra directamente ligada a que la cantidad de carbono suministrada por el sustrato no fue suficiente para un desarrollo normal de las células bacterianas.
De otro lado, en el nutriente 1 se dio un crecimiento celular importante, situación esperada, debido a que en este caso se evaluaron las concentraciones teóricas de los componentes reportados en otros estudios, sin embargo, se evidenció un mayor incremento celular en los nutrientes 3A, 3B y 3C, debido a que con éstos se querían evaluar concentraciones más altas de cachaza y eliminar el uso de la levadura. Como se mencionó anteriormente, la cachaza tiene una relación aproximada de C:N de 49.22:1 y Tortosa (2012) reportó en sus estudios, que la relación requerida por un microorganismo en el suelo para realizar correctamente sus funciones vitales es alrededor de 30:1, por ende se proporcionó una mayor disponibilidad de carbono y de otros nutrientes necesarios para que los microorganismos proliferaran en el medio de cultivo. Por otro lado, en ninguno de los 8 nutrientes evaluados se logró obtener precipitación de carbonato de calcio ya que las pruebas de efervescencia arrojaron resultados negativos, situación que se asocia principalmente a que no se ajustó el pH del medio. Autores como Hammes y Verstraete (2002) destacan el papel que tiene esta variable sobre el metabolismo microbiano para que se dé la producción de CaCO3 y resaltan la importancia de propiciar alcalinidad al medio de cultivo para que la precipitación ocurra. Es por ello que en el segundo montaje se ajustó el pH de los medios de cultivo a 8, 9 y 10, evaluando los nutrientes 3A, 3B y 3C que fue donde se evidenció un mayor crecimiento bacteriano (Figura 7).
Los halos blancos más grandes que se formaron alrededor de los microorganismos se dieron a un pH de 8 (Figura 7), ello dio un indicio cualitativo de que se presentó precipitación de carbonato de calcio por las bacterias en los medios de cultivo. Valencia (2009) y Cezario et al., 2017, evaluaron 8 y 8.2 unidades de pH respectivamente en sus investigaciones, en las cuales obtuvieron resultados similares con respecto a la producción de CaCO3 por parte de las bacterias en los nutrientes que estudiaron. En cuanto a los pH 9 y 10 se observó un comportamiento similar en los nutrientes 3A y 3B para ambos pH, ya que, si bien se observa un crecimiento bacteriano, el halo que se formó a su alrededor tiene casi los mismos tamaños y no es tan grande como en el pH 8. Esta situación posiblemente está asociada a que un incremento en el pH del medio crea un ambiente estresante para las bacterias al alterar la estabilidad de la membrana celular y, por lo tanto, afecta el intercambio de hidrogeniones o incluso puede desnaturalizar las enzimas de la célula. Hammes y Verstraete (2002) explican que cuando se tienen pH alcalinos y además iones de calcio en el medio de cultivo, el ambiente se vuelve estresante para las bacterias ya que se alteran los gradientes electroquímicos de la pared celular haciendo que se acumule Ca2+ al interior de la célula y que, a su vez, se expulsen protones en exceso. Esto se traduce en una situación perjudicial para la célula bacteriana porque ésta ya no es capaz de regular sus niveles internos de calcio, alcalinizando el pH intracelular, lo que ocasiona un agotamiento de la reserva de protones necesarios para otras funciones vitales de la bacteria. En el nutriente 3C a los pH 9 y 10 se observó un comportamiento similar, los halos alrededor de los microorganismos sembrados son grandes en comparación con los obtenidos en los mismos pH para los nutrientes 3A y 3B. Como se mencionó anteriormente ello se debe a que existe una mayor disponibilidad de materia orgánica, carbono, nitrógeno y otros nutrientes, que posiblemente compensan el estrés ambiental generado por el incremento en el pH para las células. Adicionalmente, se confirmó cualitativamente la presencia de carbonato de calcio en todos los medios de cultivo, a partir de la prueba de efervescencia y se realizaron pruebas de catalasa para verificar la presencia de microorganismos del grupo Bacillus sembrados en los tres nutrientes que se estaban evaluando; los resultados fueron positivos en todos los casos.
Finalmente, en el tercer montaje microbiológico fue posible encontrar la capacidad de bioprecipitación de cada una de las cepas aisladas (Figura 8), mediante los halos de carbonato de mayor tamaño.
Figura 8 Tercer montaje experimental con las cepas aisladas de halos más grandes a un pH de 8 en los nutrientes 3A, 3B y 3C.
Del tercer montaje experimental se pudo determinar que para el nutriente 3A, las colonias 1, 2, 7, 9 y 11 fueron las que presentaron un halo blanco de mayor tamaño en torno a la línea de bacterias sembradas, en el caso del nutriente 3B, se presentó el mismo fenómeno para todas las colonias exceptuando la número 3 y para el nutriente 3C en las colonias 1, 2, 4, 7, 8, 10 y 11. En el caso de la prueba de efervescencia, se realizaron en todos los medios de cultivo para verificar si había presencia de CaCO3 y fue posible afirmar que se dio precipitación de carbonato en los tres nutrientes en casi la mayoría de las cepas seleccionadas exceptuando las colonias 3 y 6, lo que fue debido principalmente a la resiliencia microbiana por parte de las bacterias estudiadas, ya que cada población tiene diferentes formas de adaptarse a las condiciones del medio, de dicha capacidad de adaptación dependerá su supervivencia y su capacidad de bioprecipitación. Con los tres montajes microbiológicos realizados para la evaluación del sustrato se obtuvieron resultados positivos que dieron paso a probar dicho nutriente en el suelo.
3.5 Ensayos mecánicos en las probetas
Las 24 probetas correspondientes a las muestras evaluadas con y sin adición de nutriente se sometieron a ensayos de compresión simple pasados 28 días de curado (Tabla 5).
Tabla 5 Resultados de los ensayos de compresión simple ejecutados en las probetas de suelo con y sin adición de nutriente después de 28 días de curado.
| Muestra | Humedad (%) | Fuerza (kN) | Esfuerzo (kPa) | Esfuerzo promedio (%) | Desviación estándar | Mejora respecto al control (%) | Mejora respecto a la cal (%) |
|---|---|---|---|---|---|---|---|
| Control 1 | 45% | 1.02 | 54.7 | 54.6 | 0.12 | - | - |
| Control 2 | 45% | 1.02 | 54.6 | - | - | ||
| Control 3 | 45% | 1.02 | 54.4 | - | - | ||
| Control Cal 1 | 45% | 1.20 | 64.0 | 64.2 | 0.17 | - | - |
| Control Cal 2 | 45% | 1.20 | 64.3 | - | - | ||
| Control Cal 3 | 45% | 1.20 | 64.2 | - | - | ||
| 3A 1 | 2% (+) | 1.30 | 68.5 | 68.3 | 0.15 | 25.3 | 6.5 |
| 3A 2 | 2% (+) | 1.31 | 68.2 | ||||
| 3A 3 | 2% (+) | 1.30 | 68.4 | ||||
| 3A 1 | 4% (+) | 1.22 | 64.3 | 64.3 | 0.09 | 17.8 | 0.1 |
| 3A 2 | 4% (+) | 1.22 | 64.3 | ||||
| 3A 3 | 4% (+) | 1.22 | 64.2 | ||||
| 3B 1 | 2% (+) | 1.35 | 71.4 | 71.5 | 0.32 | 31.1 | 11.4 |
| 3B 2 | 2% (+) | 1.36 | 71.2 | ||||
| 3B 3 | 2% (+) | 1.36 | 71.9 | ||||
| 3B 1 | 4% (+) | 1.24 | 65.9 | 66.1 | 0.7 | 21.1 | 3.0 |
| 3B 2 | 4% (+) | 1.28 | 66.9 | ||||
| 3B 3 | 4% (+) | 1.28 | 65.5 | ||||
| 3C 1 | 2% (+) | 1.42 | 75.0 | 74.6 | 0.4 | 36.7 | 16.2 |
| 3C 2 | 2% (+) | 1.43 | 74.2 | ||||
| 3C 3 | 2% (+) | 1.42 | 74.5 | ||||
| 3C 1 | 4% (+) | 1.20 | 62.7 | 62.7 | 0.1 | 14.9 | -2.3 |
| 3C 2 | 4% (+) | 1.20 | 62.6 | ||||
| 3C 3 | 4% (+) | 1.20 | 62.8 |
Para las muestras estudiadas el mayor esfuerzo se presentó cuando se dio un incremento en la humedad del 2%, obteniendo esfuerzos máximos promedio de 68.3, 71.5 y 74.6 kPa para los nutrientes 3A, 3B y 3C respectivamente (Figura 9). El esfuerzo máximo que se logró en este caso fue para el nutriente 3C, que corresponde a la mayor concentración de cachaza, lo que indica que tanto el contenido de humedad en la muestra como la proporción de nutrientes facilitaron las condiciones ambientales para que los microorganismos pudieran bioprecipitar CaCO3 mejorando la resistencia a esfuerzos de compresión de las probetas.

Figura 9 Esfuerzos máximos promedio alcanzados con un incremento en la humedad del 2% adicionando nutriente.
En cuanto al incremento en la humedad del 4% también se dio una mejora en los esfuerzos máximos promedio (Figura 10), para los nutrientes 3A, 3B y 3C éstos fueron 64.3, 66.1 y 62.7 kPa respectivamente. El mayor esfuerzo promedio se obtuvo para el nutriente 3B correspondiente a una concentración media de cachaza, sin embargo éste no fue mayor al obtenido con la adición de 2%, lo que está asociado posiblemente a las interacciones de los microorganismos con el sustrato en el suelo, pues al tener una menor disponibilidad de poros con las relaciones correctas de agua y aire combinado con el estrés ambiental proporcionado por el nutriente, es factible que las bacterias se sobresaturaran disminuyendo sus rendimientos. Además, es necesario evaluar otros contenidos de humedad, ya que este factor también pudo incidir en la disminución en la resistencia del material al ser sometido a fuerzas de compresión.

Figura 10 Esfuerzos máximos promedio alcanzados con un incremento en la humedad del 4% adicionando nutriente.
Como se mencionó anteriormente, el nutriente 3C con una adición de sustrato de 2% logró la mejora más relevante, siendo ésta de un 36.7 % respecto al control y de un 16.2 % con relación al control con cal. Dicha mejora es importante teniendo en cuenta que de toda la humedad suministrada a la muestra solamente el 2 y el 4% correspondían a una adición de nutriente, lo que invita a plantear otros escenarios para encontrar humedades óptimas que permitan obtener rendimientos mayores.
Finalmente, una vez se fallaron las probetas fue posible observar algunas formaciones de CaCO3 al interior de éstas (Figura 11).
Finalmente, haciendo un análisis de costo-beneficio, se concluye que usar el nutriente también tiene otras ventajas, por una parte según información suministrada por Valencia en nuestro país elaborar 1L de B4 cuesta alrededor de $2'000.000 de pesos colombianos, mientras que el sustrato usado (Cachaza de caña de azúcar) tiene un costo casi nulo ya que la cachaza es un residuo que generalmente no se aprovecha y 1000 g de cal tienen un precio de $700 pesos colombianos, de los cuales sólo se usan 7.3 g para elaborar 1L de dicho nutriente y adicionalmente, según Salazar et al. (2009), la industria panelera tiene una huella ecológica de aproximadamente 70 ha/ año o incluso más si son trapiches no tecnificados, por tanto al usar este residuo para mejorar la resistencia de los BTC se contribuye enormemente a la reducción de dicha huella. También se impide que se hagan vertimientos incontrolados en el suelo por su inadecuada disposición y se evita propiciar la eutrofización de las fuentes de agua ya que tiene un alto contenido de DQO.
4. Conclusión
Cualitativamente se pudo observar que en los nutrientes 3A, 3B y 3C a un p H de 8 se formaron los halos más grandes carbonato de calcio, especialmente en las colonias 1, 2, 7 y 11. Sin embargo, al realizar las pruebas de efervescencia, se evidenció que en casi todas las colonias se obtuvo una reacción positiva exceptuando las colonias 3 y 6, lo que indicó que los organismos evaluados tienen capacidad de precipitar el carbonato de calcio al ser bioestimuladas con el nutriente evaluado. El esfuerzo máximo obtenido de los ensayos de compresión simple efectuados en las probetas de suelo fue de 74.6 kPa con el nutriente 3C, lo que representa una mejora en la resistencia a los esfuerzos de compresión del 36.7 % respecto al control y de un 16.2 % con relación al control con cal. Esto evidencia los beneficios de usar el nutriente estudiado en esta investigación.

















